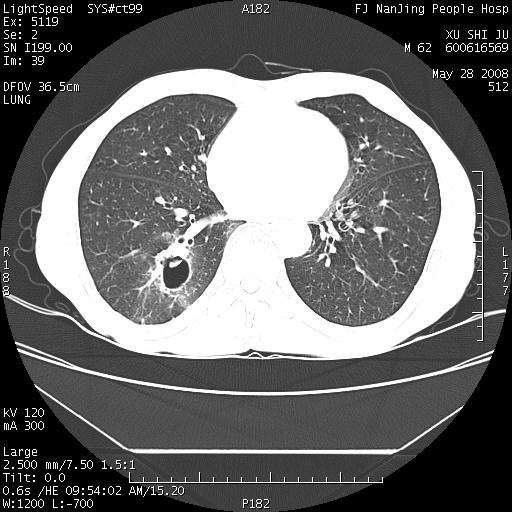
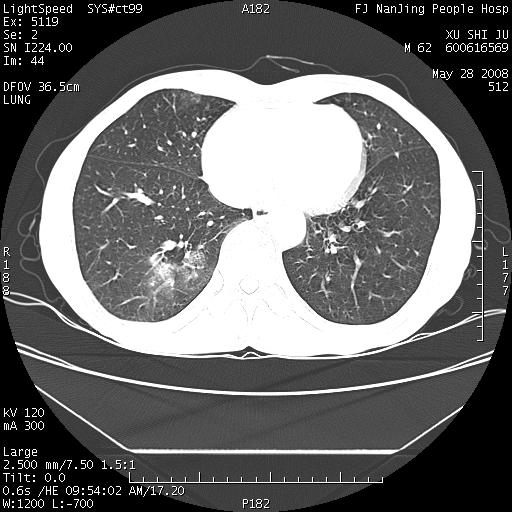

以下是引用杀毒软件在2008-5-28 19:16:00的发言:[br]病灶旁“晕轮征”,考虑肺真菌病
以下是引用qiushi在2008-5-28 20:01:00的发言:[br]空洞周围环状磨玻璃影(日晕征),考虑肺曲霉菌病.

以下是引用clj20在2008-5-28 20:50:00的发言:[br]鉴别诊断:癌性空洞壁结节。建议变换体位ct透视.[br][br]
以下是引用yuhongjun在2008-5-29 4:28:00的发言:[br]空洞周围环状磨玻璃影(日晕征),考虑肺曲霉菌病。支持! [br] [br]
以下是引用lrj在2008-5-28 21:10:00的发言:[br]所示应该是正常结构,是对称的,多个层面都有!也不像是内乳动脉或是肿大淋巴结![br]右下肺渗出性病变伴空洞形成,其洞内见一结节,以下诊断都有可能:1 右下肺曲菌感染, 2右下肺结核空洞形成伴曲菌感染!3右下肺结核空洞伴壁内占位形成,虽说后者发生的几率很低 但作为我们应该多考虑一下吧!最重要的结合临床
| 欢迎光临 医影在线 (http://bbs.radida.com/bbs/) | Powered by Discuz! X3.2 |